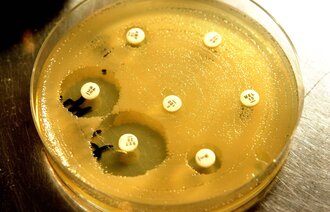
Bildet viser antibiotikaresistente bakterier i en petriskål

Overlege Anlaug Vatne fikk Forbedringsprisen

Anlaug Vatne og hennes kolleger klarte å redusere bruken av antibiotika til nyfødte med 70 prosent.
Anlaug Vatne er overlege ved nyfødtintensiven ved Stavanger universitetssykehus. I dag, 31. oktober, fikk hun Forbedringsprisen overrakt av helseminister Bent Høie.
Vatne og hennes kolleger klarte å redusere bruken av antibiotika til nyfødte som er født til termin, med 70 prosent.
– Mens 1,4 prosent av de nyfødte tidligere fikk antibiotika unødvendig, er tallet nå redusert til 0,4 prosent, sa Vatne.
Et nasjonalt satsingsområde
– Nyfødtmedisin har ikke fått så mye oppmerksomhet nasjonalt, og det er store forskjeller mellom helseforetakene. Bekjempelse av overforbruk av antibiotika er et nasjonalt, politisk satsingsområde. Det er derfor spesielt gledelig å dele ut årets pris nettopp innenfor nyfødtmedisin og antibiotikabruk, sa Anne-Grete Skjellanger, jurymedlem og leder av pasientsikkerhetsprogrammet I trygge hender 24–7.
En fryktet diagnose
Prisvinneren selv sa hun var stolt og beæret over tildelingen.
– Jeg har visst om at jeg skulle få prisen en stund. Det er godt å endelig kunne si det, sa Vatne.
– Sepsis er en fryktet diagnose på alle nyfødtavdelinger. Vi har hatt en holdning at det er bedre å være på den sikre siden, og starter opp antibiotikabehandling selv når vi er usikre på om den nyfødte har en infeksjon, sa Vatne.
Overlegen mener det ikke er så lurt.
– Antibiotikabehandling i seg selv innebærer en risiko. Barn kan utvikle astma, leddgikt og overvekt. I tillegg øker faren for multiresistente bakterier.
Systematisk arbeid
Vatne innførte et observasjonsskjema med timesobservasjoner av alle terminbarn som er innlagt på nyfødtintensiven, og hvor helsepersonell mistenkte infeksjon. Hun har også jobbet med simulering, internundervisning og kulturendring i avdelingen.
– Vi har gjennom vårt systematiske arbeid sørget for at de nyfødte som ikke har infeksjon, ikke får antibiotika, sier hun.

0 Kommentarer